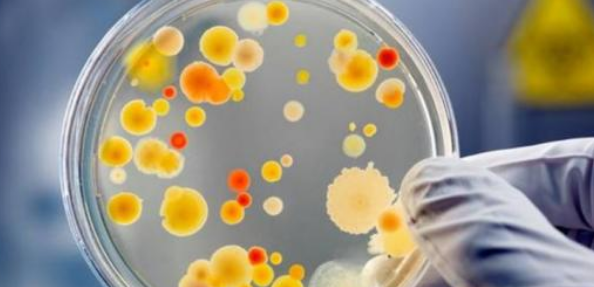
微生物方面的EI期刊有哪些

教材申报 2021-03-16
微生物包括细菌、病毒、真菌以及一些小型的原生生物、显微藻类等在内的一大类生物群体,它个体微小,与人类关系密切。涵盖了有益跟有害的众多种类,广泛涉及食品、医药、工农业、环保、体育等诸多领域。那么微生物方面的EI期刊有哪些呢?
Research in Microbiology《微生物学研究》法国 ISSN:0923-2508,1886年创刊,全年10期,Elsevier Science出版社,SCI收录期刊,SCI 2005年影响因子2.426。历史悠久的专业性学术期刊,刊载有关基础微生物学、生理学和微生物遗传学、生态学、应用微生物学、工业微生物学、细菌学和医学真菌学等微生物学领域的研究论文。不包括病毒学和免疫学方面的内容。
Current Opinion in Microbiology 《微生物学新见》英国 ISSN: 1369-5274, 1998年创刊,全年6期,Elsevier Science出版社,SCI收录期刊,SCI 2005年影响因子8.005。著名微生物学权威专业性学术期刊,刊载本学科的研究成果、新进展评论、重要参考资料评注和文献题录。
Enzyme and Microbial Technology《酶与微生物技术》美国 ISSN:0141-0229,1979年创刊,全年14期,Elsevier Science出版社,SCI、EI收录期刊,SCI 2005年影响因子1.705,2005年EI收录227篇。刊载生物技术的基础与应用方面的研究论文、评论、专利和文献摘要。报道相关的经济、规章和法律信息。
Microbes and Infection《微生物与感染》法国 ISSN:1286-4579,1999年创刊,全年15期,Elsevier Science出版社,SCI收录期刊,SCI 2005年影响因子3.154。主要刊载分子和细胞生物学、微生物之间的相互作用主机(病毒、细菌、寄生虫、真菌; 还朊病毒);当地感染的器官和组织的反应,包括本地及免疫病理;传染性疾病动物模型,包括防微生物非哺乳动物生物体;疫苗开发;临床和流行病学研究等方面的论文。
Food Microbiology《食品微生物学》英国 ISSN:0740-0020,1983年创刊,全年6期,Elsevier Science出版社,SCI收录期刊,SCI 2005年影响因子1.592。刊载食品微生物学方面的论文、评论、会议报告、简讯和书评,涉及食品中微生物检验的新方法、食品中微生物的发生学与生物化学、食品防腐剂、食品包装系统、食品损坏与安全、发酵食品、食品佐料和食品酶等。
Journal of Microbiological Methods《微生物学方法杂志》荷兰 ISSN:0167-7012,1983年创刊,全年12期,Elsevier Science出版社,SCI收录期刊,SCI 2005年影响因子2.297。刊载微生物学研究与测定方法方面的研究论文和评论。内容涉及微生物的遗传学、生理学及新陈代谢,食品微生物学,生物技术,环境与应用生物学,工业微生物学,真菌学,原生动物学,藻类学,医学与兽医微生物学等(病毒学与免疫学除外)。
文章名称:微生物方面的EI期刊有哪些
812751+拥有老客户
918539+评职称指导
63352+国际出版服务
819867+开具合同